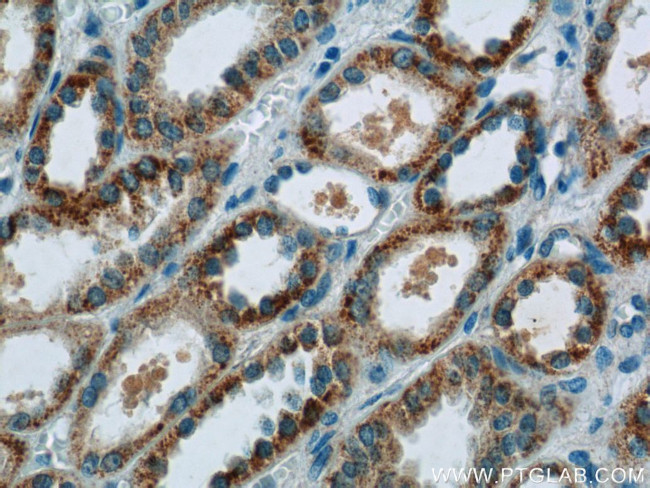
CCDC27 Antibody in Immunohistochemistry (Paraffin) (IHC (P))

Search
Proteintech
CCDC27 Polyclonal Antibody
{{$productOrderCtrl.translations['antibody.pdp.commerceCard.promotion.promotions']}}
{{$productOrderCtrl.translations['antibody.pdp.commerceCard.promotion.viewpromo']}}
{{$productOrderCtrl.translations['antibody.pdp.commerceCard.promotion.promocode']}}: {{promo.promoCode}} {{promo.promoTitle}} {{promo.promoDescription}}. {{$productOrderCtrl.translations['antibody.pdp.commerceCard.promotion.learnmore']}}
产品信息
23769-1-AP
种属反应
宿主/亚型
分类
类型
抗原
偶联物
形式
浓度
规格
纯化类型
保存液
内含物
保存条件
运输条件
产品详细信息
Immunogen sequence: SVHEEGSEE EEEEEGDRDE DSEERELPEE EEIPRRRASS LAESFEEELL AQLEEYEQVI LDFQFNLEAT RTRYSLATGV IASLQQQVDF QETQLRKINT ENETLQKELR ERRQQLQAMT DKFSNLREDK KHQEMMGLIE KDNQLLRQQV SELERKLTKR DCVISELDTK VSQLQEQVEL DQNHLQRWKQ LQEDLQSKKE MIQQAEQHTR VALESSQSRL ERLRNKIIQA TFSISGTKSL ANEISDNDIL EALQRIISER SDYYNQLKQK GVKVPPLQQS EAFLTSKSKK GTSK (364-656 aa encoded by B C112108)
靶标信息
The gene CCDC27 is part of a family of genes that encode coiled-coil domain-containing proteins. These proteins are characterized by their structural motif-a coiled-coil domain, which consists of two or more alpha helices coiled together. While specific details about CCDC27 are not thoroughly documented in the literature, coiled-coil domain proteins are known for their diverse roles in cellular structure and function, including participation in intracellular transport, signal transduction, and cellular scaffolding. Although the role of CCDC27 within these processes remains speculative, similar coiled-coil domain proteins are implicated in cancer pathogenesis due to their involvement in cellular processes that are frequently dysregulated in oncogenesis.
仅用于科研。不用于诊断过程。未经明确授权不得转售。
篇参考文献 (0)
生物信息学
蛋白别名: Coiled-coil domain-containing protein 27; RP1-286D6.1; unnamed protein product
基因别名: CCDC27
UniProt ID: (Human) Q2M243
Entrez Gene ID: (Human) 148870